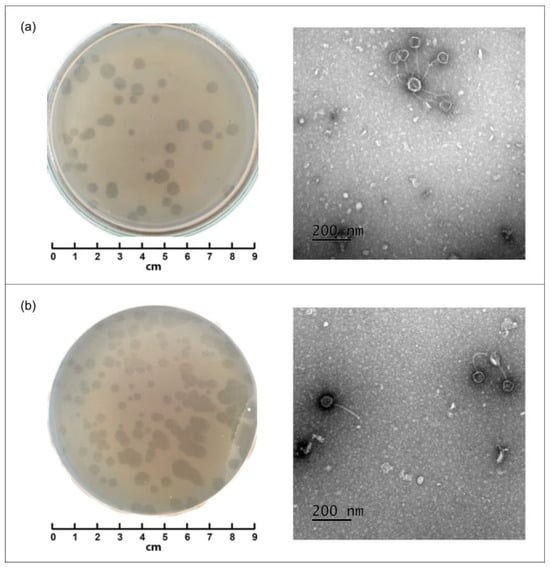

-
Small Molecule Compounds Inhibit Varicella-Zoster Virus Replication by Targeting the Portal Protein–Capsid Interface -
Interferons Inhibit Ebola Virus Infection of Human Keratinocytes -
NSC95397 Is a Novel HIV-1 Latency-Reversing Agent -
Intersegment Recombination During Influenza A Virus Replication Gives Rise to a Novel Class of Defective Viral Genomes
Journal Description
Viruses
Viruses
is a peer-reviewed, open access journal of virology, published monthly online by MDPI. The Spanish Society for Virology (SEV), Canadian Society for Virology (CSV), Italian Society for Virology (SIV-ISV), Australasian Virology Society (AVS), Brazilian Society for Virology (BSV) and Global Virus Network (GVN) are affiliated with Viruses and their members receive a discount on the article processing charges.
- Open Access— free for readers, with article processing charges (APC) paid by authors or their institutions.
- High Visibility: indexed within Scopus, SCIE (Web of Science), PubMed, MEDLINE, PMC, Embase, PubAg, and other databases.
- Journal Rank: JCR - Q2 (Virology) / CiteScore - Q1 (Virology/Infectious Diseases)
- Rapid Publication: manuscripts are peer-reviewed and a first decision is provided to authors approximately 17.2 days after submission; acceptance to publication is undertaken in 2.7 days (median values for papers published in this journal in the second half of 2025).
- Recognition of Reviewers: reviewers who provide timely, thorough peer-review reports receive vouchers entitling them to a discount on the APC of their next publication in any MDPI journal, in appreciation of the work done.
- Companion journal: Zoonotic Diseases.
Impact Factor:
3.5 (2024);
5-Year Impact Factor:
3.7 (2024)
Latest Articles
CRISPR-Based Detection of Viral Hemorrhagic Fevers at the Point of Care
Viruses 2026, 18(2), 218; https://doi.org/10.3390/v18020218 (registering DOI) - 7 Feb 2026
Abstract
Viral hemorrhagic fevers (VHFs) are highly lethal diseases that often present non-specific, influenza-like symptoms in their early stages, making clinical recognition and differentiation from other febrile illnesses difficult. This overlap underscores the critical need for diagnostic tests that are both sensitive and specific.
[...] Read more.
Viral hemorrhagic fevers (VHFs) are highly lethal diseases that often present non-specific, influenza-like symptoms in their early stages, making clinical recognition and differentiation from other febrile illnesses difficult. This overlap underscores the critical need for diagnostic tests that are both sensitive and specific. Point-of-care (POC) diagnostic tests are an invaluable tool for detecting and controlling the spread of pathogens that threaten public health, such as VHFs, as these require fast, accurate diagnostics to ensure biosafety and appropriate mobilization of resources during outbreaks. Current molecular and serological diagnostic tests, while efficient and effective, lack the characteristics required of a POC test (POCT) to quickly and easily respond to a VHF outbreak while maintaining a low cost. Clustered regularly interspaced short palindromic repeats (CRISPR)-based diagnostic tests have gained popularity as POCTs due to their inherent attractive qualities, including high sensitivity and specificity, adaptability, low cost, quick turnaround time, and ease of use. However, studies on the development of CRISPR-based POC diagnostic tests for VHFs are limited. This review summarizes the current CRISPR-based POCTs for VHFs, including Ebola virus (EBOV), Lassa virus (LASV), Dengue virus (DENV), and Crimean–Congo hemorrhagic fever virus (CCHF). The isothermal pre-amplification methods commonly paired with CRISPR-based tests, such as loop-mediated isothermal amplification (LAMP) and recombinase polymerase amplification (RPA), are also discussed.
Full article
(This article belongs to the Special Issue Virus Biosensing)
►
Show Figures
Open AccessArticle
Seroprevalence and Epidemiological Characteristics of Severe Fever with Thrombocytopenia Syndrome in Patients with Chronic Diseases in Korea
by
Jongyoun Yi, Ahreum Kim, Maeng Seok Noh, Changhoon Kim, Hyun Jin Son, Mee Kyung Ko and Kye-Hyung Kim
Viruses 2026, 18(2), 217; https://doi.org/10.3390/v18020217 - 6 Feb 2026
Abstract
Severe fever with thrombocytopenia syndrome (SFTS) is a tick-borne disease with a high mortality rate. While research has focused on high-risk rural populations and healthy individuals in endemic regions, such as Jeju Island, data on patients with underlying chronic diseases remain limited. This
[...] Read more.
Severe fever with thrombocytopenia syndrome (SFTS) is a tick-borne disease with a high mortality rate. While research has focused on high-risk rural populations and healthy individuals in endemic regions, such as Jeju Island, data on patients with underlying chronic diseases remain limited. This study aimed to evaluate the seroprevalence of SFTS virus (SFTSV) in patients with various chronic diseases across the Republic of Korea. Serum samples (N = 2948) collected from 10 regional biobanks between 2009 and 2019 were analyzed using a double-antigen sandwich enzyme-linked immunosorbent assay. The overall seroprevalence was 1.22% (36/2948). Seropositivity was significantly higher in males (1.73%) than in females (0.73%, p = 0.013) and increased with age (p = 0.001), peaking at 2.73% in individuals aged 70–79. Geographically, the highest rates were in Gyeongbuk (3.03%), Jeonnam (2.40%), and Gangwon (1.83%). Multivariable logistic regression showed older age (adjusted odds ratio 1.47 per 10-year increase, 95% confidence interval: 1.12–1.97) as the strongest independent predictor of seropositivity. Patients with hepatobiliary/pancreatic cancer (3.16%) and prostate cancer (2.50%) exhibited higher seroprevalence than those in other disease groups. SFTSV exposure is non-negligible among those with chronic diseases, particularly older males in rural provinces. Public health strategies should specifically address these vulnerable populations.
Full article
(This article belongs to the Special Issue Severe Fever with Thrombocytopenia Syndrome Virus 2026)
Open AccessReview
Human Prion Disease: Pathogenesis, Diagnosis and Public Health
by
Paola Bellini, Francesco Ruggiero, Andrea Benedetti, Carlo W. Cereda, Claudio Gobbi, Giovanni Bianco and Marco Bongiovanni
Viruses 2026, 18(2), 216; https://doi.org/10.3390/v18020216 - 6 Feb 2026
Abstract
Background: Prion diseases represent a group of rare, progressive, and invariably fatal neurodegenerative disorders. Their hallmark is the infectious nature of the misfolded prion protein (PrP^Sc), which propagates by inducing conformational changes in the physiological form (PrP^C). Despite advances in basic science,
[...] Read more.
Background: Prion diseases represent a group of rare, progressive, and invariably fatal neurodegenerative disorders. Their hallmark is the infectious nature of the misfolded prion protein (PrP^Sc), which propagates by inducing conformational changes in the physiological form (PrP^C). Despite advances in basic science, these disorders still pose major clinical and therapeutic challenges. Methods: A narrative review of the scientific literature was conducted across major biomedical databases, including PubMed, Scopus, Web of Science, and Google Scholar, covering publications up to January 2025. In addition, we describe an illustrative clinical case of a young patient with probable iatrogenic Creutzfeldt–Jakob disease following corneal transplantation, used to highlight diagnostic uncertainty and infection-control implications. Findings: Evidence confirms that PrP^Sc drives neurodegenerative processes and transmissibility, with phenotypic and genetic variants influencing clinical course and prognosis. From a diagnostic perspective, neuroimaging techniques and cerebrospinal fluid biomarkers have undergone substantial refinement, with RT-QuIC emerging as a highly specific and sensitive assay. Therapeutic options remain unsatisfactory: no treatment has shown a significant impact on survival. However, innovative strategies (including monoclonal antibodies, gene-based interventions, and modulation of PrP^C) represent promising avenues of investigation. Conclusions: Prion diseases remain an unresolved challenge at the intersection of neurology and infectious diseases. Earlier diagnosis through advanced biomarkers and continued development of targeted therapies are essential to improve patient management, while the persistence of iatrogenic cases underscores the ongoing relevance of surveillance and preventive strategies in clinical practice.
Full article
(This article belongs to the Section Prions)
►▼
Show Figures

Figure 1
Open AccessArticle
Beyond Foodborne HAV: Sexual Transmission Drives a New Wave of Cases in Romania
by
Adrian Paun, Irina Ianache, Ruxandra Moroti, Georgiana Pomohaci, Gratiela Tardei, Mike Youle, Simona Ruta and Cristiana Oprea
Viruses 2026, 18(2), 215; https://doi.org/10.3390/v18020215 - 6 Feb 2026
Abstract
Background: In 2022, Romania experienced a sharp increase in hepatitis A virus (HAV) infections, with evidence of predominant fecal–oral transmission through sexual contact, raising concern for an outbreak among men who have sex with men (MSM). Methods: We conducted a prospective
[...] Read more.
Background: In 2022, Romania experienced a sharp increase in hepatitis A virus (HAV) infections, with evidence of predominant fecal–oral transmission through sexual contact, raising concern for an outbreak among men who have sex with men (MSM). Methods: We conducted a prospective multicenter study between 1 March 2022 and 1 March 2023 in two tertiary hospitals in Bucharest. HAV infection was defined by a compatible clinical presentation, elevated liver enzymes, and positive anti-HAV IgM serology. Clinical and laboratory characteristics were compared by transmission route and HIV status. Results: A total of 191 patients were diagnosed with HAV, including 105 MSM and 86 with foodborne transmission. All were unvaccinated. Most patients were male (82.2%), with a median age of 30 years (IQR 24–38). MSM were significantly younger and reported higher-risk sexual behaviors, including chemsex and multiple or occasional partners (p < 0.0001). Among MSM, 48 (25.1%) were living with HIV, most with preserved immune status and undetectable viral loads. Clinical manifestations were similar across groups, with jaundice being most frequent (89.5%). However, MSM exhibited more severe hepatocellular injury, reflected by higher ASAT and ALAT levels and lower prothrombin concentration, independent of HIV status. MSM were also more likely to have concomitant sexually transmitted infections, including syphilis and mpox (p < 0.001). Disease was predominantly mild, although MSM had longer hospital stays. Conclusions: The 2022 HAV surge in Romania was driven by both sexual and foodborne transmission. Targeted HAV vaccination, along with integrated sexual health services and harm-reduction strategies, is essential to prevent future outbreaks.
Full article
(This article belongs to the Special Issue HIV and Viral Hepatitis Co-Infection)
Open AccessArticle
Isolation and Genomic Characterization of Two Lytic Cutibacterium acnes Phages Defines Two Novel Pahexavirus Species
by
Anastasia A. Vorobeva, Aleksei M. Vorobev, Peter V. Evseev, Emil R. Mekhtiev, Andrei V. Chaplin, Maria A. Pasivkina, Ekaterina S. Zubkova, Svetlana S. Bochkareva, Mikhail A. Yaitsky, Nikolai A. Nikitin, Natalia B. Demina, Victoria A. Korol, Andrei V. Aleshkin, Anatolij N. Blintsov and Maria N. Anurova
Viruses 2026, 18(2), 214; https://doi.org/10.3390/v18020214 - 6 Feb 2026
Abstract
Bacteriophages are promising antibacterial agents for managing acne vulgaris caused by Cutibacterium acnes, particularly given increasing antibiotic resistance. Here, we isolated and characterized two lytic Cutibacterium phages, NS-ph1 and NS-ph2, from acne lesions. Both bacteriophages exhibited a broad lytic spectrum, with a
[...] Read more.
Bacteriophages are promising antibacterial agents for managing acne vulgaris caused by Cutibacterium acnes, particularly given increasing antibiotic resistance. Here, we isolated and characterized two lytic Cutibacterium phages, NS-ph1 and NS-ph2, from acne lesions. Both bacteriophages exhibited a broad lytic spectrum, with a high activity against 27 C. acnes strains. Adsorption assays indicated rapid attachment and one-step growth experiments revealed latent periods of 4 h (NS-ph1) and 2 h (NS-ph2) and burst sizes of 70 and 59 PFU per infected cell, respectively. After long-term storage at room temperature, both phages retained infectivity for 3 months. Genome sequencing revealed linear dsDNA genomes of 29,490 bp (NS-ph1) and 29,189 bp (NS-ph2) with 51 and 46 predicted ORFs, respectively, and no tRNAs. No genes associated with lysogeny, toxins, or antibiotic resistance were detected. Comparative genomics placed both phages within the genus Pahexavirus. Together, these data expand the diversity of Pahexavirus and provide two well-characterized lytic candidates for further evaluation in anti-acne phage therapy.
Full article
(This article belongs to the Section Bacterial Viruses)
►▼
Show Figures
Figure 1
Open AccessBrief Report
Human Herpesvirus 6-Associated Miller–Fisher Syndrome in a 5-Year-Old Child: A Case-Based Narrative Review of Pediatric Cases with Infectious Triggers
by
Ho-Young Song, Kyu Young Chae and Sung-Ha Kim
Viruses 2026, 18(2), 213; https://doi.org/10.3390/v18020213 - 6 Feb 2026
Abstract
Background/Objectives: Miller–Fisher syndrome (MFS) is a rare Guillain–Barré variant defined by ophthalmoplegia, ataxia, and areflexia. Pediatric MFS is uncommon, and infectious triggers remain underrecognized. Human herpesvirus 6 (HHV-6) is neurotropic but rarely linked to immune-mediated neuropathies. In this paper, we describe a child
[...] Read more.
Background/Objectives: Miller–Fisher syndrome (MFS) is a rare Guillain–Barré variant defined by ophthalmoplegia, ataxia, and areflexia. Pediatric MFS is uncommon, and infectious triggers remain underrecognized. Human herpesvirus 6 (HHV-6) is neurotropic but rarely linked to immune-mediated neuropathies. In this paper, we describe a child with MFS associated with HHV-6 detected in cerebrospinal fluid (CSF) and review reported pediatric infections related to MFS. Methods: A 5-year-old girl presented with acute ophthalmoplegia, ataxia, and diminished reflexes. Neuroimaging, ophthalmologic tests, CSF analyses, and serologic andpolymerase chain reaction (PCR) assays were performed, including multiplex reverse transcription–PCR of cerebrospinal fluid using the BioFire® Meningitis/Encephalitis panel. A literature search was performed on Pubmed to identify pediatric (0–18 years) MFS cases with infectious triggers. Two reviewers independently screened and summarized the literature, and a PRISMA-style flow diagram was used to transparently report the study selection process. Results: HHV-6 DNA was detected via CSF PCR twice, while tests for other pathogens were negative. Anti-GQ1b and related antibodies were negative or borderline. The patient received intravenous immunoglobulin and corticosteroids, with full recovery after one month. Among 20 published pediatric cases (1997–2021), Campylobacter jejuni was most frequent, followed by Mycoplasma pneumoniae and influenza viruses. Anti-GQ1b IgM positivity and favorable outcomes were commonly reported, including cases managed conservatively. Conclusions: This case raises the hypothesis that HHV-6 may represent a potential post-infectious association in pediatric MFS. The review findings indicate that pediatric MFS generally follows infection, responds well to immunotherapy, and has an excellent prognosis. Viral testing may be considered in selected, hypothesis-generating contexts in atypical or seronegative pediatric MFS presentations.
Full article
(This article belongs to the Section Human Virology and Viral Diseases)
►▼
Show Figures

Figure 1
Open AccessReview
Avian Influenza H5N1 Infection During Pregnancy: Preparing for the Next Flu Pandemic and Improving Perinatal Outcomes
by
Matthew J. Zuber, Callie L. Brown and Cara B. Janusz
Viruses 2026, 18(2), 212; https://doi.org/10.3390/v18020212 - 6 Feb 2026
Abstract
Influenza (flu) is a common respiratory virus with seasonal global spread. Zoonotic viruses can occasionally cross species, leading to pandemic-level spread, and for flu viruses, this is considered an “antigenic shift”. The flu can be particularly severe during pregnancy due to immune system
[...] Read more.
Influenza (flu) is a common respiratory virus with seasonal global spread. Zoonotic viruses can occasionally cross species, leading to pandemic-level spread, and for flu viruses, this is considered an “antigenic shift”. The flu can be particularly severe during pregnancy due to immune system adaptations that occur during pregnancy, with prior global pandemics causing excess hospitalizations, deaths, and other complications in the mothers and the neonates. We aim to review the current literature with respect to novel avian H5N1 and the potential impact of infection with flu during pregnancy. A systematic literature search was conducted. Here we provide a rapid summary of epidemiology and understanding of viral spread, published risks of H5N1 in pregnancy, the unique physiologic, cellular, and molecular adaptations making H5N1 infection unique in pregnancy, implementation of an effective vaccine program in event of a pandemic specific to pregnant individuals, optimizing peripartum care for infected individuals, and direction for future research to direct vaccine strategy and mitigate risks in a future flu pandemic.
Full article
(This article belongs to the Special Issue H5N1 Influenza Viruses)
►▼
Show Figures

Figure 1
Open AccessArticle
A Unified Framework to Prioritize RNA Virus Cross-Species Transmission Risk Across an Expansive Host Landscape
by
Di Zhao, Yi-Fei Wang, Zu-Fei Yin, Ya-Fei Wu, Hui-Jun Yu, Luo-Yuan Xia, Xiao-He Liu, Xiao-Ming Cui, Xiao-Yu Shi, Dai-Yun Zhu, Na Jia, Jia-Fu Jiang, Wu-Chun Cao and Wenqiang Shi
Viruses 2026, 18(2), 211; https://doi.org/10.3390/v18020211 - 5 Feb 2026
Abstract
RNA viruses exhibit high mutation rates and strong host adaptive capacity, posing major public health challenges. Although meta-transcriptomic studies have uncovered vast numbers of novel RNA viral sequences, identifying those with spillover risks remains difficult. Current virus host-prediction methods can only predict a
[...] Read more.
RNA viruses exhibit high mutation rates and strong host adaptive capacity, posing major public health challenges. Although meta-transcriptomic studies have uncovered vast numbers of novel RNA viral sequences, identifying those with spillover risks remains difficult. Current virus host-prediction methods can only predict a narrow set of host labels at coarse taxonomic levels (e.g., kingdom or order), which hampers precise evaluation of cross-species transmission risk and may overlook potential zoonotic hosts. To overcome these limitations, we developed UniVH, a unified virus–host association prediction framework trained on an exceptionally broad spectrum of 90 viral families and 240 host families, enabling robust prediction even for phylogenetically distant or data-scarce hosts. UniVH achieved a host prediction accuracy of 71.2% for novel viruses discovered after 2020, representing a 15.3% improvement over conventional BLASTp-based homology approaches. Feature interpretation revealed that viral structural genes and host immune- and metabolism-related genes contributed most significantly to predictive performance. Model predictions indicated widespread host-range expansion, with 20 mammalian virus families doubling their documented mammalian host ranges and several showing marked increases in viruses with human-infection potential. This unified, interpretable framework represents an important methodological advance for future RNA virus spillover-risk evaluation and emerging virus prioritization.
Full article
(This article belongs to the Section General Virology)
Open AccessArticle
Genomic Evolution of Influenza A(H1N1)pdm09 and A/H3N2 Viruses Among Children in Wuhan, China, Spanning the COVID-19 Pandemic (2020–2023)
by
Muhammad Arif Rizwan, Ying Li, Jiaming Huang, Haizhou Liu, Muhammad Noman, Ismaila Damilare Isiaka, Hebin Chen, Wenqing Li, Yuehu Liu, Huaying Wang, Yuyi Xiao, Yi Yan, Xiaoxia Lu and Di Liu
Viruses 2026, 18(2), 210; https://doi.org/10.3390/v18020210 - 5 Feb 2026
Abstract
Despite the persistent global threat of seasonal influenza viruses such as A(H1N1)pdm09 and A/H3N2, their epidemiological and genetic characteristics in China following the implementation of COVID-19 non-pharmaceutical interventions (NPIs) remain poorly characterized. Between September 2020 and December 2023, we conducted an integrated epidemiological
[...] Read more.
Despite the persistent global threat of seasonal influenza viruses such as A(H1N1)pdm09 and A/H3N2, their epidemiological and genetic characteristics in China following the implementation of COVID-19 non-pharmaceutical interventions (NPIs) remain poorly characterized. Between September 2020 and December 2023, we conducted an integrated epidemiological and genomic analysis of influenza A viruses in children in Wuhan. The overall positivity rate for influenza A virus was markedly low at 3.43% (109/3171), reflecting a profound suppression of circulation during the pandemic. Among genotyped positives, H1N1pdm09 was predominant (52.3%), followed by H3N2 (16.5%) and untypeable strains (32.1%). Preschool children showed the highest susceptibility. Phylogenetic analysis revealed that the circulating H1N1 strains (90%) belonged to clade 6B.1A.5a.2, clustering with viruses from Hong Kong and Pakistan. In contrast, H3N2 strains (76.92%) primarily fell into clade 3C.2a1b.2a.2b, closely related to contemporary strains from Europe and North America. Notably, we identified key hemagglutinin mutations associated with antigenic drift (e.g., R240Q in H1N1; E78G, R158G in H3N2) and neuraminidase mutations potentially conferring antiviral resistance (e.g., S247N in H1N1; S245N, a putative novel glycosylation site, in H3N2). Evidence of reassortment events was also detected, underscoring the continued genomic evolution of these viruses despite their low prevalence. Our findings demonstrate that genetically diverse and antigenically drifted influenza A viruses continued to circulate and evolve in Wuhan during the COVID-19 pandemic, albeit at dramatically reduced levels. This highlights the critical need for sustained genomic surveillance and timely updates of vaccine compositions to pre-empt the resurgence of influenza in the post-pandemic era.
Full article
(This article belongs to the Special Issue Antigenic Drift in Respiratory Viruses)
►▼
Show Figures

Figure 1
Open AccessArticle
HIV Membrane-Proximal External Region Scaffolded Immunogen as Killed Whole-Cell Genome-Reduced Vaccines
by
Juan Sebastian Quintero-Barbosa, Yufeng Song, Frances Mehl, Shubham Mathur, Lauren Livingston, Peter D. Kwong, Xiaoying Shen, David C. Montefiori and Steven L. Zeichner
Viruses 2026, 18(2), 209; https://doi.org/10.3390/v18020209 - 5 Feb 2026
Abstract
Background: Killed Whole Cell Genome-Reduced Bacteria (KWC/GRB), a versatile vaccine platform, can produce very low cost, thermostable, easily manufactured vaccines expressing complex immunogens that include potent immunomodulators. This system supports iterative optimization through a Design–Build–Test–Learn (DBTL) workflow aimed at enhancing immunogenicity. We applied
[...] Read more.
Background: Killed Whole Cell Genome-Reduced Bacteria (KWC/GRB), a versatile vaccine platform, can produce very low cost, thermostable, easily manufactured vaccines expressing complex immunogens that include potent immunomodulators. This system supports iterative optimization through a Design–Build–Test–Learn (DBTL) workflow aimed at enhancing immunogenicity. We applied this approach to developing HIV-1 gp41 Membrane-Proximal External Region (MPER) vaccines using the scaffolded MPER antigen, 3AGJ, a recombinant heterologous protein engineered to mimic MPER structures recognized by broadly neutralizing monoclonal antibodies (bNAbs). Methods: Five KWC/GRB vaccines expressing versions of 3AGJ were designed, including versions linked to immunomodulators and multimers of the immunogen. Display on the surface of the bacteria was evaluated by flow cytometry using the broadly neutralizing monoclonal antibody 2F5. Outbred HET3 mice were vaccinated intramuscularly, and MPER-specific antibody responses were assessed by ELISA and by the ability of the vaccines to induce neutralizing antibodies. Neutralization was measured against tier 1 and tier 2 HIV-1 pseudoviruses. Results: All five vaccines were strongly expressed on the bacterial surface and induced clear MPER-specific antibody responses in every mouse. About 33% of the animals showed detectable HIV-1 neutralization. Conclusions: These results demonstrate that a KWC/GRB-based scaffold-MPER (3AGJ) vaccine can elicit HIV-1 neutralizing antibodies in a subset of animals. Although further optimization will be required to improve the consistency and magnitude of neutralizing responses, the findings provide an initial validation of the concept. There are many strategies that can be used to enhance and extend immune responses induced by KWC/GRB vaccines that can be employed to yield improved anti-HIV-1 immune responses.
Full article
(This article belongs to the Section Viral Immunology, Vaccines, and Antivirals)
►▼
Show Figures

Figure 1
Open AccessArticle
Elucidating the Molecular Mechanism of 3D1 Antibody Binding to a Swine Enteric Coronavirus Antigen
by
Liangminghui Zhang, Ze Liang, Guang Yang and Lei Yan
Viruses 2026, 18(2), 208; https://doi.org/10.3390/v18020208 - 5 Feb 2026
Abstract
The broadly neutralizing monoclonal antibody 3D1 potently neutralizes SADS-CoV by targeting a conserved epitope within the heptad repeat 1 (HR1) domain of the viral spike protein. Structural and biophysical analyses demonstrate that 3D1 binds with high affinity to a specific linear β-turn motif
[...] Read more.
The broadly neutralizing monoclonal antibody 3D1 potently neutralizes SADS-CoV by targeting a conserved epitope within the heptad repeat 1 (HR1) domain of the viral spike protein. Structural and biophysical analyses demonstrate that 3D1 binds with high affinity to a specific linear β-turn motif (residues A804–N809) in HR1. High-resolution crystallography reveals that this motif sits within a deep, electrostatically complementary paratope groove. Critically, 3D1 binding competitively inhibits the essential interaction between HR1 and HR2. Notably, its recognition is not dependent on HR1’s native helical conformation, as it maintains strong binding to conformationally constrained, stapled helical peptides. Collectively, the data indicate that 3D1 neutralizes by capturing a pre-hairpin intermediate state of HR1—a transition state between prefusion and postfusion forms—thereby sterically blocking the formation of the stable postfusion six-helix bundle that is essential for membrane fusion. This work defines a precise, structure-dependent neutralizing epitope and elucidates a mechanism of action that involves trapping a key fusion intermediate, offering a valuable template for the design of broad-spectrum coronavirus therapeutics.
Full article
(This article belongs to the Special Issue Coronavirus Therapy: Antiviral Drugs and Anti-Inflammatory Immunopharmacology)
►▼
Show Figures

Figure 1
Open AccessReview
Feline Rotavirus A as a Source of Spillover Infections to Humans: An In-Depth Analysis of Molecular Epidemiological Evidence
by
Osamu Nakagomi and Toyoko Nakagomi
Viruses 2026, 18(2), 207; https://doi.org/10.3390/v18020207 - 5 Feb 2026
Abstract
Rotavirus A (RVA) is a leading cause of severe diarrhoea in children, and interspecies transmission significantly drives the genomic diversity of human RVAs. Cats represent a key host species, requiring in-depth analysis regarding RVA transmission to humans. This review evaluated the literature on
[...] Read more.
Rotavirus A (RVA) is a leading cause of severe diarrhoea in children, and interspecies transmission significantly drives the genomic diversity of human RVAs. Cats represent a key host species, requiring in-depth analysis regarding RVA transmission to humans. This review evaluated the literature on the complex genotype constellations of feline RVAs in relation to relevant canine and human RVAs to define the role of feline RVAs in the evolutionary history of human strains. The review traces the methodological shift from genogrouping by RNA-RNA hybridisation to the current genotype constellation system enabled by whole-genome sequencing. While early methods identified a shared genomic closeness between human AU-1 and feline FRV-1, whole-genome sequencing indicated that several human RVA strains, including AU-1, HCR3A, and Ro1845, likely resulted from direct transmission of feline/canine strains, due to shared genotype constellations and high sequence identity with animal strains like feline FRV-1, Cat97 and canine CU-1. Evidence of reassortment—such as the emergence of G1P[9] and G9P[9] strains after the feline-derived G3P[9] crossed into the human population—suggests these feline-like strains have successfully overcome the host-species barrier and are capable of onward human-to-human transmission, not just dead-end spillover events. However, definitive confirmation of sustained transmission or contemporary spillover requires stringent phylogenetic criteria: multiple human strains with >99% identical sequences in a monophyletic lineage for sustained transmission, or an identical human–feline pair across all genome segments for contemporary spillover. Confirming the status of the AU-1-like constellation as a third, low-frequency human RVA type requires future studies applying these strict criteria.
Full article
(This article belongs to the Special Issue Insights into Feline Viruses: Molecular, Structural, Pathogenic, and Clinical Aspects)
►▼
Show Figures

Figure 1
Open AccessArticle
Screening of Rubella Virus, Cytomegalovirus, Hepatitis B Virus, Hepatitis C Virus, HIV, Syphilis, and Toxoplasma gondii Antibodies in Pregnant Women
by
Fatih Mehmet Akıllı, Fatih Demir and Taylan Onat
Viruses 2026, 18(2), 206; https://doi.org/10.3390/v18020206 - 5 Feb 2026
Abstract
TORCH pathogens are often asymptomatic in healthy adults but can cause foetal death when transmitted during pregnancy; therefore, accurate regional data are essential for screening. This study aimed to determine first-trimester TORCH seropositivity and to inform the development of hospital-based and national screening
[...] Read more.
TORCH pathogens are often asymptomatic in healthy adults but can cause foetal death when transmitted during pregnancy; therefore, accurate regional data are essential for screening. This study aimed to determine first-trimester TORCH seropositivity and to inform the development of hospital-based and national screening algorithms. This study analysed test results from 7481 pregnant women aged 15–49 years who participated between January 2020 and December 2024. TORCH serological results obtained using the MAGLUMI X3/X6 system (Snibe, Shenzhen, China) were analysed with Statistical Package for the Social Sciences. Anti-HCV positivity was 0.12% (9/7166), anti-Toxoplasma gondii IgG positivity was 16.5% (1027/6204), anti-rubella IgG positivity was 95.5% (5809/6080), and anti-CMV IgG positivity was 98.69% (6130/6211). Syphilis seropositivity among pregnant women was 0.2% (13/4991). Significant differences by age groups (15–24, 25–34, and >35 years) were observed for rubella IgG (p < 0.001), T. gondii IgG (p < 0.001), and HBsAg positivity (p = 0.009). This study investigated TORCH seropositivity among pregnant women in our hospital region and underscores the need for targeted public health initiatives to reduce the risk of congenital infections. It recommends systematic first-trimester assessment of TORCH exposure, standardized data recordings, the establishment of national screening programmes, and careful consideration of testing costs.
Full article
(This article belongs to the Section Human Virology and Viral Diseases)
►▼
Show Figures

Figure 1
Open AccessSystematic Review
A Systematic Review of Methodological Approaches to SARS-CoV-2 Wastewater Surveillance
by
György Deák, Laura Lupu and Raluca Prangate
Viruses 2026, 18(2), 205; https://doi.org/10.3390/v18020205 - 4 Feb 2026
Abstract
Following the COVID-19 pandemic, researchers have increasingly focused on monitoring the spread of the virus and improving methods to detect changes in the SARS-CoV-2 genome. Although clinical surveillance provides direct and reliable results, it has limited applicability. Wastewater-based epidemiology (WBE) has therefore emerged
[...] Read more.
Following the COVID-19 pandemic, researchers have increasingly focused on monitoring the spread of the virus and improving methods to detect changes in the SARS-CoV-2 genome. Although clinical surveillance provides direct and reliable results, it has limited applicability. Wastewater-based epidemiology (WBE) has therefore emerged as a valuable, non-invasive complementary tool for disease surveillance. It provides a comprehensive picture of virus circulation in a population, including asymptomatic individuals and those who do not seek healthcare. In addition, it facilitates early detection of outbreaks and the collection of epidemiologic data at the community level. However, WBE also presents technical challenges, including variations in sampling and testing protocols, the presence of inhibitors that affect viral RNA extraction, and the need for standardised procedures between studies. These challenges should be addressed for possible future infectious disease outbreaks. One of the challenges facing researchers was to develop efficient methods that could overcome the extraction and detection problems related to inhibitors present in wastewater. To this aim, this systematic review highlights the potential use of WBE, the variety of techniques, and the most effective methods for the detection and quantification of SARS-CoV-2 in wastewater samples. A reproducible electronic search of the literature was conducted in the Web of Science (WoS) and PubMed databases for articles published between 2020 and 2024. Our search revealed that the majority of observed WBE applications emphasised a correlation between SARS-CoV-2 RNA concentration trends in wastewater and epidemiological data. Another relevant issue that the articles often discussed and compared was the techniques used in different steps of sample processing, such as sample collection, concentration and detection, hence the lack of standardised procedures. This paper provides a framework regarding previous research on WBE to gain a better understanding that will lead to functional solutions.
Full article
(This article belongs to the Special Issue Wastewater-Based Epidemiology and Viral Surveillance)
►▼
Show Figures

Graphical abstract
Open AccessArticle
Single-Cell Transcriptomic Profile Associated with Sub-Subtype A6 and CRF63-02A6 HIV-1 Strain Infection
by
Kirill Elfimov, Anna Khozyainova, Ludmila Gotfrid, Dmitriy Baboshko, Dmitry Kapustin, Polina Achigecheva, Vasiliy Ekushov, Maksim Hakilov, Mariya Gashnikova, Tatyana Bauer, Tatyana Tregubchak, Andrey Murzin, Arina Kiryakina, Aleksei Totmenin, Aleksandr Agaphonov and Natalya Gashnikova
Viruses 2026, 18(2), 204; https://doi.org/10.3390/v18020204 - 4 Feb 2026
Abstract
We present the single-cell transcriptomic analysis of peripheral blood mononuclear cells (PBMC) from individuals during acute HIV-1 infection caused by viral strains circulating in Russia and the Former Soviet Union (FSU) countries. Using 10x Genomics single-cell RNA sequencing (scRNA-seq) on the Illumina NextSeq
[...] Read more.
We present the single-cell transcriptomic analysis of peripheral blood mononuclear cells (PBMC) from individuals during acute HIV-1 infection caused by viral strains circulating in Russia and the Former Soviet Union (FSU) countries. Using 10x Genomics single-cell RNA sequencing (scRNA-seq) on the Illumina NextSeq 550 platform, we have analyzed scRNA-seq data from three treatment-naive patients (viral load > 1 × 106 copies/mL, estimated infection duration ≤ 4 weeks) and three healthy donors. Data integration (Seurat, Harmony), automated cell-type annotation (CellTypist), and GeneOntology (GO) enrichment analysis for highly expressed and low-expressed genes revealed a profound reorganization of transcriptional programs across key immune populations, including memory CD4+ and CD8+ T cells, non-classical monocytes and natural killer cells (NK-cells). We observed signatures of hyperactivation of pro-inflammatory pathways (NF-kB, TNF, and type I/II interferon signaling), upregulation of genes associated with cellular migration (CXCR4, CCR7) and metabolic adaptation (oxidative phosphorylation components), alongside a mixed pro- and anti-apoptotic expression profile. Notably, our data pointed to a pronounced dysregulation of the TGF-β and mTOR signaling cascades, disrupted intercellular communication networks—particularly between cytotoxic cells and their regulators—altered expression of genes implicated in disease progression (OLR1, SERPINB2, COPS9) and viral persistence control (NEAT1, NAF1). This work provides an initial single-cell transcriptional atlas characterizing early immune responses to HIV-1 sub-subtypes A6 and CRF63_02A6, the predominant drivers of the HIV epidemic across the FSU region.
Full article
(This article belongs to the Special Issue Molecular Insights into HIV-1 Infection)
►▼
Show Figures

Figure 1
Open AccessArticle
Type II Restriction of 2-Aminoadenosine (dZ)-Modified DNA and Production of dZ-Modified Plasmid in E. coli
by
Weiwei Yang, Michael S. Kuska, Nan Dai, Laurence M. Ettwiller, Ivan R. Corrêa, Jr. and Shuang-Yong Xu
Viruses 2026, 18(2), 203; https://doi.org/10.3390/v18020203 - 4 Feb 2026
Abstract
The modified DNA base 2,6 aminopurine (2-aminoadenine, (d)Z base) was originally found in phages to counteract host-encoded restriction systems. However, only a limited number of restriction endonucleases (REases) have been tested on dZ-modified DNA. Here, we report the activity results of 147 REases
[...] Read more.
The modified DNA base 2,6 aminopurine (2-aminoadenine, (d)Z base) was originally found in phages to counteract host-encoded restriction systems. However, only a limited number of restriction endonucleases (REases) have been tested on dZ-modified DNA. Here, we report the activity results of 147 REases on dZ-modified PCR DNA. Among the enzymes tested, 53% are resistant or partially resistant, and 47% are sensitive when their restriction sites contain one to six modified bases. Sites with four to six dZ substitutions are most likely to resist Type II restriction. Our results support the notion that dZ-modified phage genomes evolved to combat host-encoded restriction systems. dZ-modified DNA can also reduce phage T5 exonuclease degradation, but has no effect on RecBCD digestion. When two genes for dZ biosynthesis and one gene for dATP hydrolysis from Salmonella phage PMBT28 (purZ (adenylosuccinate synthetase), datZ (dATP triphosphohydrolase), and mazZ ((d)GTP-specific diphosphohydrolase) were cloned into an E. coli plasmid, the level of dZ incorporation reached 19–20% of adenosine positions. dZ levels further increased to 29–44% with co-expression of a DNA polymerase gene from the same phage. High levels of dZ incorporation in recombinant plasmid are possible by co-expression of purZ, mazZ, datZ and phage DNA helicase, dpoZ (DNA polymerase) and ssb (single-stranded DNA binding protein SSB). This work expands our understanding of the dZ modification of DNA and opens new avenues for engineering restriction systems and therapeutic applications.
Full article
(This article belongs to the Section Bacterial Viruses)
Open AccessArticle
Prolyl tRNA Synthetase Is Required for Mammarenavirus Multiplication
by
Haydar Witwit, Pablo Ibanez, Ruifeng Zhou, Nathaniel Jackson, Ruby Escobedo, Beatrice Cubitt, Roaa Khafaji, Rachel Y. Sattler, Luis Martinez-Sobrido and Juan Carlos de la Torre
Viruses 2026, 18(2), 202; https://doi.org/10.3390/v18020202 - 4 Feb 2026
Abstract
Several mammarenaviruses (MaAv), chiefly Lassa virus (LASV) in Western Africa and Junin virus (JUNV) in the Argentinean Pampas, cause severe disease in humans and pose important public health problems in their endemic regions. In addition, the globally distributed MaAv lymphocytic choriomeningitis virus (LCMV)
[...] Read more.
Several mammarenaviruses (MaAv), chiefly Lassa virus (LASV) in Western Africa and Junin virus (JUNV) in the Argentinean Pampas, cause severe disease in humans and pose important public health problems in their endemic regions. In addition, the globally distributed MaAv lymphocytic choriomeningitis virus (LCMV) is an underrecognized human pathogen of clinical significance, especially in congenital infections, and LCMV poses a serious risk for immunocompromised individuals. There are no FDA-approved MaAv vaccines or antivirals, and current anti-MaAv therapy is limited to an off-label use of ribavirin, whose efficacy remains controversial. This highlights an urgent unmet need for developing antivirals against human pathogenic MaAv. Halofuginone (HF), a derivative of the natural alkaloid febrifugine, has been shown to exhibit antiviral activity against several RNA viruses. Here, we present evidence that HF exhibits potent dose-dependent antiviral activity against LCMV, and against the hemorrhagic fever causing MaAv LASV and JUNV. HF binds to the bifunctional enzyme glutamyl-prolyl-tRNA synthetase 1 (EPRS1) and specifically inhibits its prolyl-tRNA synthetase (PRS) activity, resulting in translation inhibition via the amino acid starvation (AAS) response with preferential impact on proline-rich proteins. HF anti-LCMV activity was prevented by the addition of exogenous proline supporting that inhibition of PRS activity plays a critical role in the anti-MaAv activity of HF. We found that HF did not affect LCMV cell entry, modestly (twofold) reduced the activity of the virus ribonucleoprotein (vRNP), but strongly inhibited (>90%) Z budding activity, a process involving the Z proline-rich late domain motifs.
Full article
(This article belongs to the Section Viral Immunology, Vaccines, and Antivirals)
►▼
Show Figures

Graphical abstract
Open AccessArticle
Single-Cell Sequencing Reveals the Immune Characteristics of Secondary Liver Injury Induced Indirectly by CHIKV Infection in Rhesus Macaques
by
Hao Yang, Yun Yang, Cong Tang, Yanan Zhou, Wenhai Yu, Qing Huang, Haixuan Wang, Daoju Wu, Wenqi Quan, Junbin Wang and Shuaiyao Lu
Viruses 2026, 18(2), 201; https://doi.org/10.3390/v18020201 - 3 Feb 2026
Abstract
Chikungunya virus (CHIKV) is now prevalent in multiple regions worldwide, posing a serious threat to human health. In this study, we have successfully established a rhesus macaque model of Chikungunya virus infection. Notably, while no viral load was detected in liver tissue on
[...] Read more.
Chikungunya virus (CHIKV) is now prevalent in multiple regions worldwide, posing a serious threat to human health. In this study, we have successfully established a rhesus macaque model of Chikungunya virus infection. Notably, while no viral load was detected in liver tissue on day 7 post-infection, significant pathological damage was observed. Single-cell RNA sequencing of liver tissue revealed a reduction in B cells following infection. Among T cells, CD8+ T and NKT cells mediated major cytotoxic effects, whereas CD4+ T and memory T cells primarily exerted regulatory functions that further enhanced the activation of CD8+ T and NKT cells. In macrophages, inflammatory macrophages fc gamma R-mediated phagocytosis upregulated, with multiple key activation-related genes being highly upregulated. Furthermore, we observed that there might be a potential bidirectional activation effect between T cells and macrophages. These results indicate that CHIKV-induced indirect liver injury is likely mediated not only by the virus itself but also, in part, by the activation of hepatic immune cells.
Full article
(This article belongs to the Special Issue Chikungunya Virus in Viral Immunology and Vaccine Research)
►▼
Show Figures

Figure 1
Open AccessCase Report
Unilateral and Reversible Hypoglossal Nerve Palsy in Infectious Mononucleosis Syndromes: Two Rare Cases from Our Clinic
by
Gheorghiță Jugulete, Mădălina Maria Merișescu, Alexandra Totoianu, Mihaela Oros, Mihaela Cristina Olariu and Bianca Borcos
Viruses 2026, 18(2), 200; https://doi.org/10.3390/v18020200 - 3 Feb 2026
Abstract
Background and Clinical Significance: Hypoglossal nerve palsy is an uncommon neurological complication of infectious mononucleosis and is only rarely reported. Putative mechanisms include virus-triggered neuritis (Epstein–Barr virus (EBV) or Cytomegalovirus (CMV)) and/or mechanical compression related to cervical lymphadenopathy. Case Presentation: We report two
[...] Read more.
Background and Clinical Significance: Hypoglossal nerve palsy is an uncommon neurological complication of infectious mononucleosis and is only rarely reported. Putative mechanisms include virus-triggered neuritis (Epstein–Barr virus (EBV) or Cytomegalovirus (CMV)) and/or mechanical compression related to cervical lymphadenopathy. Case Presentation: We report two children with infectious mononucleosis and transient unilateral hypoglossal nerve palsy. Case 1 was a 15-year-old boy with 7 days of fever and typical mononucleosis features who developed leftward tongue deviation accompanied by sialorrhea, dysarthria, and dysphagia. Laboratory testing showed marked hepatocellular injury and EBV-specific IgM positivity. Case 2 was a 9-year-old girl with a 24 h history of bilateral lateral cervical lymphadenopathy with overlying inflammatory signs; examination revealed rightward tongue deviation with similar associated symptoms. CMV-specific IgM antibodies were detected on serological testing. Both patients received systemic corticosteroids and empiric intravenous antibiotics, with supportive care. Hypoglossal nerve function fully recovered within 2–4 weeks of treatment initiation. Conclusions: These cases underscore that isolated hypoglossal nerve palsy may complicate EBV- or CMV-associated mononucleosis in children. Although the prognosis is generally favorable, the presentation warrants careful evaluation to exclude alternative causes of lower cranial neuropathies and close follow-up until complete neurological resolution.
Full article
(This article belongs to the Special Issue EBV and Disease: New Perspectives in the Post COVID-19 Era)
►▼
Show Figures

Figure 1
Open AccessArticle
HIV Infection as an Independent Factor Accelerating Epigenetic Ageing in Men Treated with Integrase Inhibitors: A Case–Control Study
by
Mateusz Bożejko, Małgorzata Małodobra-Mazur, Andrzej Gnatowski, Monika Ołdakowska, Aleksandra Szymczak, Bartosz Szetela, Hubert Ciepłucha, Aleksander Zińczuk and Brygida Knysz
Viruses 2026, 18(2), 199; https://doi.org/10.3390/v18020199 - 2 Feb 2026
Abstract
A number of published studies suggest that HIV infection accelerates epigenetic ageing. The main aim of this study was to ascertain if HIV infection is an independent factor leading to DNA hypomethylation and accelerating epigenetic ageing in men successfully treated with integrase inhibitor
[...] Read more.
A number of published studies suggest that HIV infection accelerates epigenetic ageing. The main aim of this study was to ascertain if HIV infection is an independent factor leading to DNA hypomethylation and accelerating epigenetic ageing in men successfully treated with integrase inhibitor (INSTI)-based combined antiretroviral therapy (cART). Forty-eight (48) men living with HIV receiving INSTI-based cART and fifty (50) uninfected men in the control group were included. All participants filled out a questionnaire probing into lifestyle factors. Global and site-specific DNA methylation and expression of methyltransferase genes were examined in all participants. As well, all patients underwent basic laboratory blood tests. The results were analysed using statistical and machine learning methods. We found a strong association between HIV infection and global DNA hypomethylation as well as significant association with higher expression of the methyltransferase gene DNMT1. However, there was no association with DNA methylation levels of CNOT2, DPP6, FOXG1 and NPTX2 genes or expression levels of DNMT3a and DNMT3b. The results confirm that in men successfully treated with INSTI-based cART, HIV infection is an independent factor causing global DNA hypomethylation and increased DNMT1 expression and thus accelerating epigenetic ageing.
Full article
(This article belongs to the Section Human Virology and Viral Diseases)
►▼
Show Figures

Figure 1
Journal Menu
► ▼ Journal Menu-
- Viruses Home
- Aims & Scope
- Editorial Board
- Reviewer Board
- Topical Advisory Panel
- Instructions for Authors
- Special Issues
- Topics
- Sections & Collections
- Article Processing Charge
- Indexing & Archiving
- Editor’s Choice Articles
- Most Cited & Viewed
- Journal Statistics
- Journal History
- Journal Awards
- Society Collaborations
- Conferences
- Editorial Office
Journal Browser
► ▼ Journal BrowserHighly Accessed Articles
Latest Books
E-Mail Alert
News
Topics
Conferences
Special Issues
Special Issue in
Viruses
Infectious Disease Epidemiology: Current Updates and Perspectives
Guest Editors: Agata Skrzat-Klapaczynska, Justyna Dominika KowalskaDeadline: 10 February 2026
Special Issue in
Viruses
Role of Bacteriophage in Intestine Microbial Communities
Guest Editor: Yi DuanDeadline: 15 February 2026
Special Issue in
Viruses
Evolution and Adaptation of Avian Viruses
Guest Editors: Giovanni Franzo, Matteo LegnardiDeadline: 28 February 2026
Special Issue in
Viruses
Diversity and Evolution of Viruses in Ecosystem 2025
Guest Editor: René KalliesDeadline: 28 February 2026
Topical Collections
Topical Collection in
Viruses
Poxviruses
Collection Editors: Giliane de Souza Trindade, Galileu Barbosa Costa, Flavio Guimaraes da Fonseca
Topical Collection in
Viruses
Efficacy and Safety of Antiviral Therapy
Collection Editors: Giordano Madeddu, Andrea De Vito, Agnese Colpani




